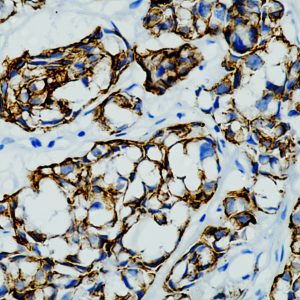
AM944
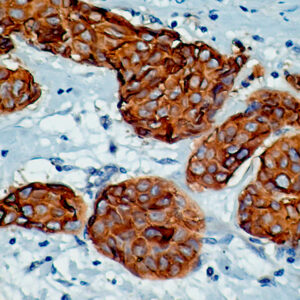
Anti-Cytokeratin 7 & 8

C
Showing 141–160 of 234 resultsSorted by latest
-

Anti-c-Jun, Clone 4H9
Price range: $269.00 through $2,539.00 Select options This product has multiple variants. The options may be chosen on the product page -

Anti-CD20/MS4A1
Price range: $475.00 through $1,205.00 Select options This product has multiple variants. The options may be chosen on the product page -

Anti-Cytokeratin 20, Clone KRT20/1992
Price range: $269.00 through $1,675.00 Select options This product has multiple variants. The options may be chosen on the product page -
Anti-Cytokeratin 7
Price range: $269.00 through $1,430.00 Select options This product has multiple variants. The options may be chosen on the product page -

Anti-CD61/Integrin B3
Read more -

Anti-CD61/Integrin B3
Price range: $269.00 through $1,329.00 Select options This product has multiple variants. The options may be chosen on the product page -

Anti-CD45
Price range: $519.00 through $1,415.00 Select options This product has multiple variants. The options may be chosen on the product page -

Anti-CD3e
Read more -

Anti-CD3e
Price range: $375.00 through $1,219.00 Select options This product has multiple variants. The options may be chosen on the product page -

Anti-CD8a
Price range: $469.00 through $1,199.00 Select options This product has multiple variants. The options may be chosen on the product page -

Anti-CD40
Read more -

Anti-CD40
Price range: $250.00 through $1,235.00 Select options This product has multiple variants. The options may be chosen on the product page -

Anti-CDK1
Read more -

Anti-CDK1
Price range: $250.00 through $1,295.00 Select options This product has multiple variants. The options may be chosen on the product page -

Anti-CD73
Read more -

Anti-CD73
Price range: $250.00 through $1,435.00 Select options This product has multiple variants. The options may be chosen on the product page -

Anti-CD7
Price range: $260.00 through $1,449.00 Select options This product has multiple variants. The options may be chosen on the product page -
Anti-Cytokeratin 7 & 8
Price range: $250.00 through $935.00 Select options This product has multiple variants. The options may be chosen on the product page -

Anti-Calretinin
Price range: $350.00 through $1,195.00 Select options This product has multiple variants. The options may be chosen on the product page -

Anti-Cytokeratin 17
Price range: $250.00 through $831.00 Select options This product has multiple variants. The options may be chosen on the product page
